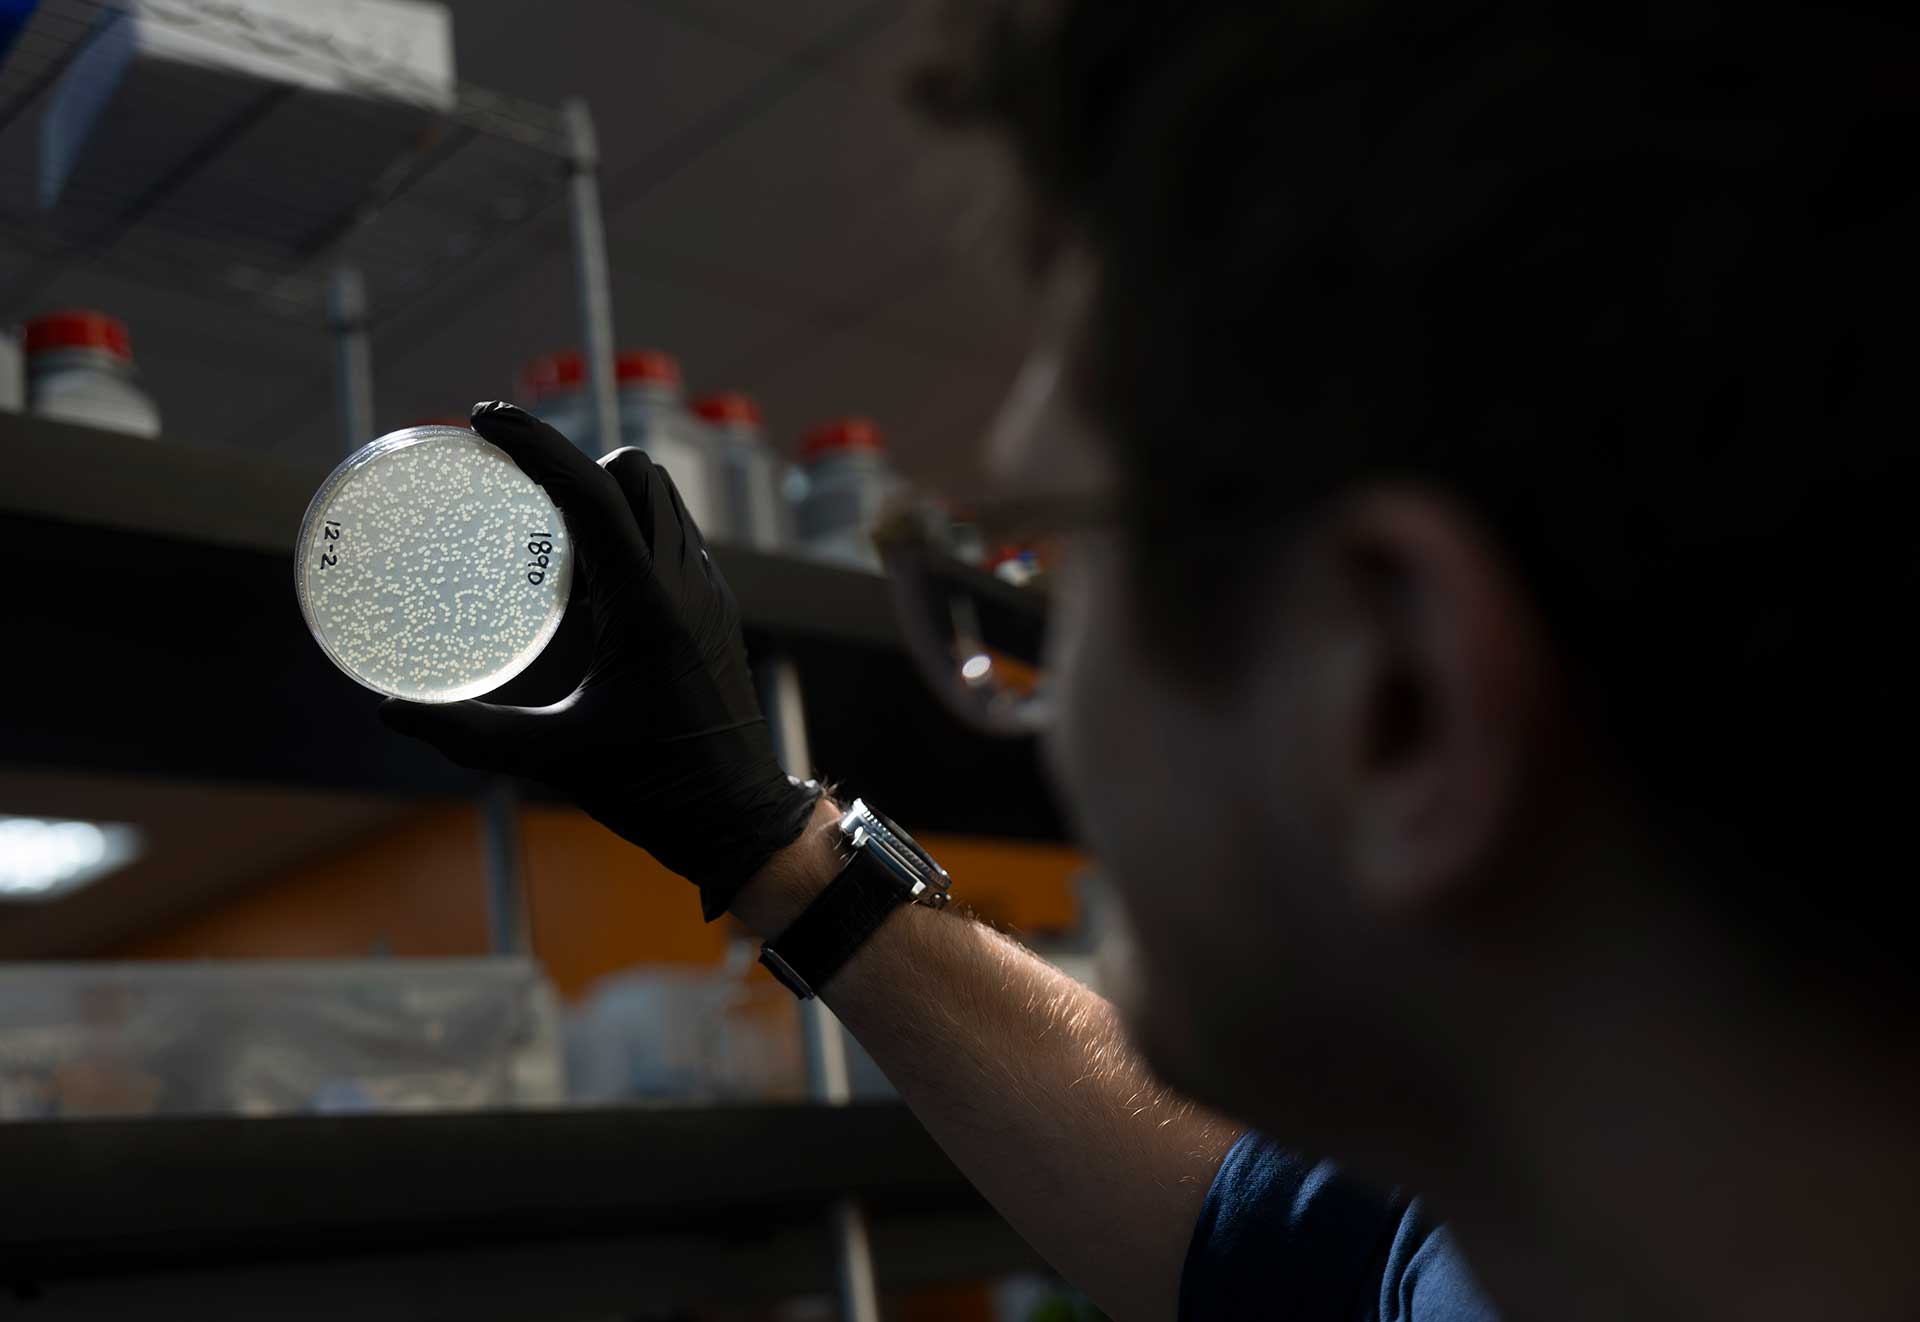
careers slider image

Unleashing DNA medicines

over 100x the expression of traditional non-viral DNA

Invisible to immune sensors that detect foreign DNA

Months to years of expression from a single dose; safely re-dosable

Low manufacturing complexity and proven LNP technology